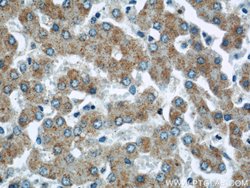
CHMP2B Rabbit anti-Human, Mouse, Rat, Polyclonal, Proteintech:Anticuerpos:Anticuerpos

missing translation for 'onlineSavingsMsg'
Learn More
Learn More
Descripción
This gene encodes a component of the heteromeric ESCRT-III complex (Endosomal Sorting Complex Required for Transport III) that functions in the recycling or degradation of cell surface receptors. ESCRT-III functions in the concentration and invagination of ubiquitinated endosomal cargos into intralumenal vesicles. The protein encoded by this gene is found as a monomer in the cytosol or as an oligomer in ESCRT-III complexes on endosomal membranes. It is expressed in neurons of all major regions of the brain. Mutations in this gene result in one form of familial frontotemporal lobar degeneration.
Especificaciones
Especificaciones
| Antígeno | CHMP2B |
| Aplicaciones | Western Blot, Immunocytochemistry, Immunohistochemistry (Paraffin), Immunofluorescence |
| Clasificación | Polyclonal |
| Concentración | 0.13 mg/mL |
| Conjugado | Unconjugated |
| Formulación | PBS with 50% glycerol and 0.02% sodium azide; pH 7.3 |
| génica | CHMP2B |
| N.º de referencia del gen | Q8BJF9, Q9UQN3 |
| Alias de gen | CHMP2.5, CHMP2B, chromatin modifying protein 2B, DMT1, hVps2 2, VPS2 2, VPS2B |
| Símbolos de los genes | Chmp2b |
| Mostrar más |
Título del producto
Al hacer clic en Enviar, acepta que Fisher Scientific se ponga en contacto con usted en relación con los comentarios que ha proporcionado en este formulario. No compartiremos su información para ningún otro fin. Toda la información de contacto proporcionada se mantendrá de acuerdo con nuestra Política de Privacidad. Política de privacidad.
¿Detecta una oportunidad de mejora?